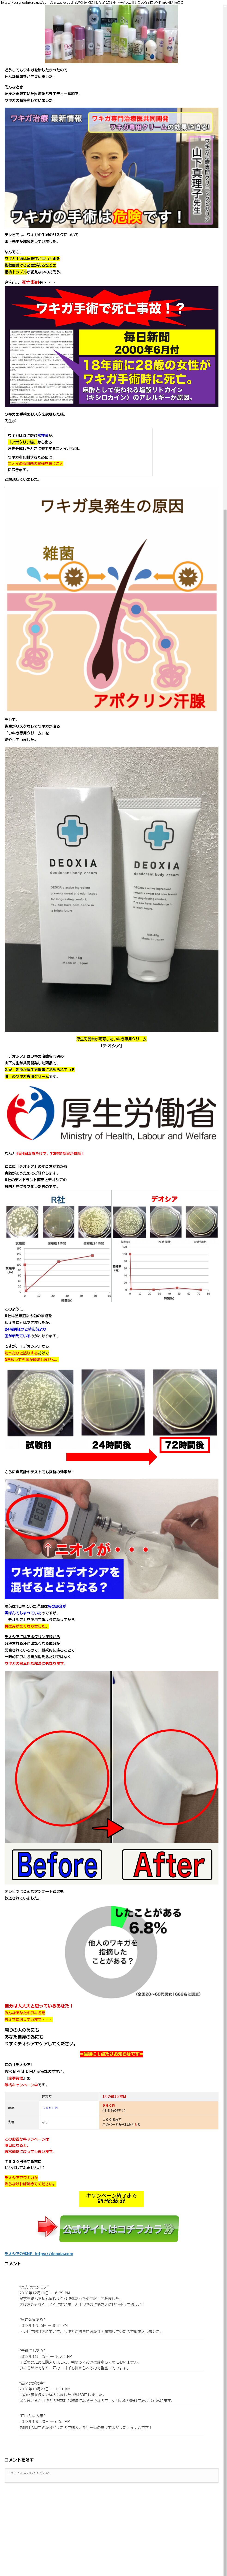

レコメンドウィジェット広告
2019年1月~2020年12月のレコメンドウィジェット広告を記録しました。
※別の広告をランダムに表示します
取得日時:2019/01/01 18:40
広告サイトキャプチャ(広告主サイト)
広告サイト 運営社情報
取得に失敗しました。Webメディア 広告枠に赤枠付き

※別の広告をランダムに表示します
created by @kazunii_ac